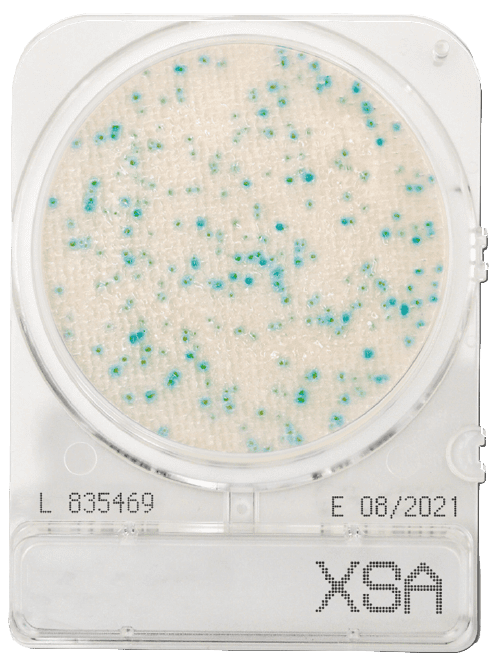

Staphylococcus aureus is one of the most common pathogens of Staphylococci. This ubiquitous microorganism is part of the human microflora naturally found on the skin, nose, and hair, and is commonly used as an index of personal hygiene in food handling and preparation.
Staphylococcus aureus is responsible for nosocomial infections and food poisoning due to enterotoxins, which can cause gastrointestinal symptoms.